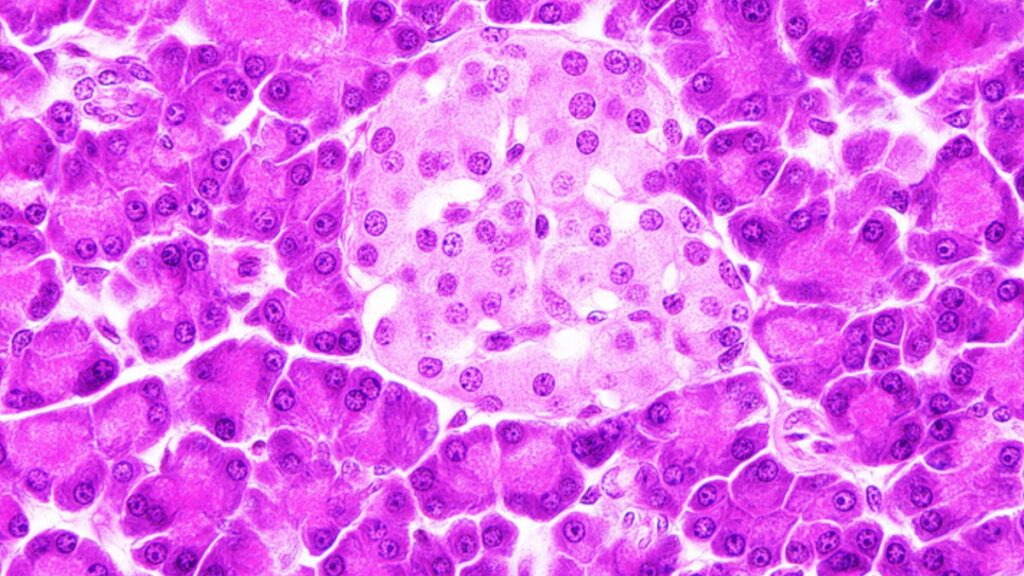

Cientistas deram um passo importante no combate ao diabetes tipo 1. Pela primeira vez, eles usaram impressão 3D com células humanas reais para fabricar estruturas que produzem insulina. A pesquisa foi apresentada no Congresso Internacional de Transplantes, em Londres, e mostrou resultados animadores para quem convive com a condição. A notícia é exclusiva e publicada pela agência de notícias Reuters. O portal “Um Diabético” conversou com a endocrinologista e pesquisadora, Denise Franco, sobre o tema.
“Nesse cenário, essa bioimpressão em 3D das ilhotas pode ser uma alternativa promissora e permite uma produção, talvez em larga escala, dessas células produtoras de insulina, das células-beta” – declara a médica.
A equipe do estudo utilizou uma biotinta especial, feita com tecido pancreático humano sem células e alginato, uma substância vinda de algas marinhas. A partir disso, os pesquisadores imprimiram células de ilhotas pancreáticas humanas, responsáveis pela produção de insulina no corpo.
Ao longo de três semanas, essas células impressas continuaram vivas e responderam bem aos testes com glicose. Elas conseguiram principalmente produzir insulina de forma eficiente e mantiveram sua estrutura estável, sem se deformar ou se degradar com o tempo.
Estrutura preservada melhora o desempenho
Diferente dos transplantes tradicionais, que retiram a estrutura de sustentação das células, o novo método manteve componentes importantes. Por isso garantiu mais sobrevivência e eficiência para as ilhotas impressas.
Além disso, as novas células responderam melhor à glicose do que os métodos atuais. No 21º dia do estudo, as ilhotas impressas mostraram uma alta capacidade de detectar e reagir aos níveis de açúcar no sangue, indicando, portanto, grande potencial clínico.
Testes em andamento com animais
Agora, a equipe de cientistas realiza testes com animais para analisar o desempenho das células em um organismo vivo. Além disso, o grupo estuda formas de armazenamento de longo prazo. O objetivo é tornar essa terapia acessível para uso em larga escala.
O pesquisador Quentin Perrier, da Faculdade de Medicina da Universidade Wake Forest, lidera o estudo. Ele destacou a importância do avanço para a agência de notícia Reuters:
“Este é um dos primeiros estudos a usar ilhotas humanas reais em vez de células animais na bioimpressão, e os resultados são incrivelmente promissores. Isso significa que estamos mais perto de criar um tratamento pronto para diabetes que poderá, um dia, eliminar a necessidade de injeções de insulina“, afirmou.
No entanto, segundo Denise, o tratamento é complexo, principalmente na questão das próximas análises, que serão feitas em animais.
“A gente pode ter diferenças bem grandes quando aplicadas no ser humano, até pela questão de vascularização, oxigenação e resposta imunológica dessas células.”
Segurança a longo prazo
Além do fator citado, a endocrinologista ainda destaca que os pesquisadores precisam realizar muitos testes para determinar a segurança a longo prazo.
“Se a gente pensar no estudo em si, ele representa o que a gente chama de prova de conceito. A gente não sabe ainda se tem viabilidade e vai depender de teste adicional para comprovar se essas células duram, se elas vão funcionar, e principalmente, acho que o mais importanten é ser segura a longo prazo. A gente não sabe ainda se essas ilhotas conseguem liberar a insulina de forma adequada, se elas respondem, por exemplo, à concentração de glicose.”
LEIA MAIS
- Quando a glicose alta passa a ser um perigo? Médica explica
- Paciente com diabetes é impedido de comprar insulina após nova regra da Anvisa para GLP-1
- É fake: pessoas com diabetes não têm isenção de IPVA ou desconto para veículos; advogada esclarece
IMAGEM DE CAPA: ilhota pancreática (rosa claro) circundada por ácinos do pâncreas exócrino (rosa escuro.) FONTE: Microscopia on line, 3v, USP.